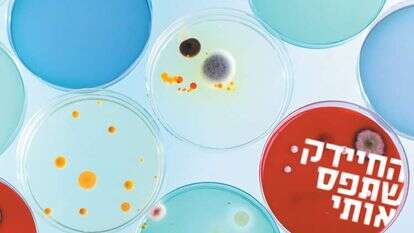
שאטרסטוק

הטובות לקרב // ד"ר עינת צחורי־פיין
גילויו של חיידק שגורם לצִרְעה ללדת בנות בלבד הביא להשקת פס ייצור של כלי נשק ביולוגיים: חרקים משודרגים שיוצאים להגן על החממות
1.ריצ'רד סטאוטהמר היה חוקר צעיר באוניברסיטת קליפורניה שבחר לשקע את עצמו בצרעות. מתוך עולם ומלואו שמציעה האנטומולוגיה, ברר לו סטאוטהמר צרעה טפילית ממין שלא קיימים בו זכרים: מכל הביצים שמטילות הצרעות, בוקעים דורות על גבי דורות של נקבות בלבד. הרבייה, אם תהיתם, היא רביית בתולין, ללא צורך בזכרים - מה שגורם לצאצאיות להיות העתק מדויק של אִמן־הורתן.
באחד הימים החליט החוקר לתת לצרעות שלו מנות אנטיביוטיקה משלושה סוגים שונים. אז התרחש דבר מוזר ומפתיע: הצרעות החלו לייצר גם זכרים. הוא חזר על הניסוי שוב ושוב, ובכל פעם מחדש אירע הנס. סטאוטהמר ושותפיו בדקו ומצאו כי בתוך הצרעות שוכן חיידק בשם וולבכיה, ומרגע שהאנטיביוטיקה מסלקת אותו, מפציעים הזכרים. למעשה, כבר שלושים שנה קודם הצליחו חוקרים לגרום לצרעות להביא בנים לעולם, אבל הם עשו זאת על ידי חימום. המחקר החדש העלה שכמו האנטיביוטיקה, גם הטמפרטורות הגבוהות העלימו את חיידק הוולבכיה.
המאמר של סטאוטהמר הופיע בשנת 1990 ב־PNAS, כתב־העת הרשמי של האקדמיה הלאומית למדעים של ארה"ב. עוד קודם לפרסומו הגיעה השמועה אל עינת צחורי־פיין, אז סטודנטית לתואר שני באנטומולוגיה באוניברסיטת קורנל. "באותם ימים עבדתי על הדברה ביולוגית של מזיקים באמצעות צרעה טפילית מסוג אנקרסיה, שגם היא מופיעה תמיד כנקבה. המחקר של סטאוטהמר נראה לי הדבר הכי מגניב שיש, והחלטתי לנסות אותו על הצרעות שלי. התברר שזה עובד גם אצלן, ובמעבדה שלי החלו 'להיוולד' זכרים. חקרתי ומצאתי שיש כאן מערכת יחסים מרתקת של תן וקח בין המארח, כלומר הצרעה, לבין הדיירים־החיידקים. מאותו רגע זנחתי את נושא המאסטר שכבר בחרתי לי, והחלטתי לעבוד על יחסי הגומלין בין חיידקים וחרקים ולרתום אותם לטובת הגנת הצומח", מספרת ד"ר צחורי־פיין - היום חוקרת בכירה בנווה יער, מרכז המחקר הצפוני של מכון וולקני.
הכי מעניין
הפספסים העניקו לחיידק את שמו הייחודי. החיידק קרדיניום

הפספסים העניקו לחיידק את שמו הייחודי. החיידק קרדיניום. | צילום: צחורי-פיין ובורציס

הקרדו הירושלמי במפת מידבא. | צילום: שאטרסטוק
כדי להבין מה לצרעות ולהרחקת מזיקים מהשדה, צריך להכיר את טיב היחסים בינן לבין החיידקים. כשהצרעה־האם מטילה ביצה, החיידקים נמצאים כבר בילט־אין בתוך תאי הצרעה שתבקע. הם משמשים עבורה ועבור חרקים אחרים כמו אברונים בתא. קחו למשל כינת ראש, שמרגע בקיעתה ועד יום מותה ניזונה מדם: התפריט הערפדי אינו מספיק לה, ולהשלמת התזונה אחראים חיידקים שדואגים לכל מחסורה ומסנתזים לה למשל ויטמין בי. גם נמלי עץ וטרמיטים מארחים באכסניית גופם חיידקים, ומקבלים בתמורה הטבות קולינריות.
"אני מתמחה בחרקים מוצצים – למשל כנימות קמחיות, שבעזרת החדק שלהן שותות את הנוזל העובר בצינורות ההובלה של הצמח", אומרת צחורי־פיין. "התזונה הזו עשירה מאוד בסוכרים, אבל ענייה מאוד בחלבונים. לכן בגוף החרקים האלה יש חיידקים, שמשלימים את החסר ומייצרים עבורם חומצות אמינו. הקשר הזה הוא מחויב המציאות. החרק לא יכול בלי החיידקים, והם לא יכולים להתקיים בלעדיו, כי הם יחד מיליוני שנים. החיידק כבר איבד את יכולות המחיה העצמאיות שלו, כך שגם לבודד אותו בצלחת זה בלתי אפשרי". מסיבה זו, היא מוסיפה, אם ניתן אנטיביוטיקה מסוימת לילד שראשו עמוס כינים, החיידקים יחוסלו והכינים ימותו בעקבותיהם – אולי גם מאבל אך בעיקר מתת־תזונה (לקחתי מרשם).
אחת ההשפעות האפשריות של החיידקים האורחים היא כאמור התערבות בוטה ביחס בין הזוויגים - שיעור הזכרים לעומת הנקבות. הוולבכיה, למשל, סובל ממיזאנדריה (שנאת גברים) קשה, ולא בכדי. כחיידק שמתקיים במערכת הרבייה, אבל תאי הזרע קטנים מדי עבורו, העדפתו הברורה תהיה תמיד ריבוי נקבות.

ד"ר עינת צחורי־פיין. | צילום: המכון הוולקני
חיידקים גם יכולים להקנות לחרק הנושא אותם מגוון יכולות – עמידות נגד פטרייה שתוקפת אותו, ניצול יעיל של מקורות מזון ועוד. "הם מעניקים למארח גמישות סביבתית וכישורי אדפטציה מהירה לתנאים המשתנים. כמובן, לכל דבר יש מחיר. כנימת עלה שמכילה חיידקים חיה פחות זמן, ויש לה פחות צאצאים. היא בערך כמו חיל האוויר שלנו: כל עוד אין מלחמה, הציוד מכביד על הכיס; ברגע שפורצת מלחמה, כדאי מאוד שיהיה ציוד. אם תיכנס למשל צרעה לחממה, יש לכנימה הזו סיכוי גבוה יותר לשרוד את האיום".
איפה המחקר הזה פוגש את עולם החקלאות וההגנה על הצומח?
"אנחנו יודעים שבמסגרת הסימביוזה – אגב, יש לה מילה יפה מאוד בעברית: צוותאות - החיידקים משפיעים על החרק בצורה רחבה, ולכן אנחנו פועלים בשני כיוונים. הראשון הוא ניסיון לשפר חרקים מועילים שאנחנו חפצים ביקרם. תחשבי למשל שאת יכולה להחדיר לדבורה חיידק שיגן עליה מפני וירוסים מאיימים. כבר עשית משהו טוב בעולם. אנחנו גם עובדים המון על הדברה ביולוגית – שימוש בצרעות טפיליות, חיפושיות טורפות וכל מה שיכול לסלק מזיקים ולחסוך חומרי הדברה. אנחנו במעבדה לוקחים חרק מועיל, ומנסים להשפיע על הסימביוזה שלו עם החיידקים כך שתשרת את הצרכים שלנו ותחזק את החיילים שלנו. מהכיוון השני אנחנו מנסים לפגוע בחרקים מזיקים, וזה כבר הרבה יותר מורכב ומסובך".
תני לי דוגמה לחרק ששדרגתם.
"לקחנו למשל צרעה טפילית שמשמשת להדברת כנימה מסוימת, נפוצה מאוד. בחנו את הרכב החיידקים שלה, ומצאנו שוב את הוולבכיה. ערכנו סדרת ניסויים וגילינו שלנוכחות החיידק יש השפעה על כשירות הצרעה, ולכן גם על ההעדפה האם לגדל אותה עם הוולבכיה או בלעדיו".

מערכת יחסים של תן וקח. צִרְעה טפילית. | צילום: שאטרסטוק
חיידק הוולבכיה, אגב, נקרא על שם סימאון וולבך, אחד משני החוקרים שגילו אותו בשנת 1924 בתאים של יתוש. צחורי־פיין וצוותה אחראים בעצמם למתן שם לחיידק אחר, וייקרא שמו בישראל (ובעולם): קרדיניום. "כמו תמיד במדע, גם אותו גילינו במקרה. חיפשנו אצל צרעות האנקרסיה את הוולבכיה, שגורם להימצאות נקבות בלבד, אבל לא מצאנו. אז עלתה בדעתנו האפשרות שיש עוד חיידק בעל השפעה דומה".
איך בוחרים שם לחיידק?
"בגדול מותר לך לתת לו איזה שם שאת רוצה, ובלבד שיתאים לחוקי הדקדוק הלטיני. רוב החיידקים קרויים על שם מי שהמגלים רצו לחלוק לו כבוד. יש חיידק בשם ריקציה שגורם למחלת הטיפוס, הוא זה שהרג לנו את מאיר אריאל. קראו לו על שם הווארד טיילור ריקטס, שמת בעצמו מטיפוס כשניסה להבין מה גורם למחלה. יש חיידקים שהשם שלהם מתאר אותם בדרך כלשהי. במקרה שלנו, כשמסתכלים על החיידק במיקרוסקופ אלקטרוני חודר, רואים שיש לו מין פסים דקים. הם הזכירו לעמיתה שלי, פרופ' יובל גוטליב, את הקרדו הירושלמי כפי שהוא מופיע במפת מידבא, וכך הגענו לשם קרדיניום. את הרוב הגדול של החיידקים עדיין לא גילינו, כך שאנו המדענים נידרש להיות יצירתיים עוד פעמים רבות בעתיד".
תרגילי בטן // ד"ר אמיר בשן
אינספור יצורים זעירים חיים בג'ונגל השוקק שהוא המעיים שלנו. הבנת האינטראקציות ביניהם עוד עשויה להניב תרופה למחלות רבות
2. יחסי השכנות בין טריליוני הדיירים הזעירים לבין המארח זוכים בשנים האחרונות להתעניינות חסרת תקדים. החל מ־2007, אז הושק בקול תרועה רמה פרויקט המיקרוביום האנושי במימון NIH (המכונים הלאומיים לבריאות של ארה"ב), מתרחבת בקרב החוקרים ההבנה כי החיים המיקרוסקופיים שרוחשים בקרבנו קריטיים משחשבו. נבחרת החיידקים של כל אחד מאיתנו - מסה של קילוגרם וחצי שיושבת ברובה במעיים, אבל לא רק שם – נתפסת היום כאיבר עצמאי וחיוני, שצריך לקחת אותו בחשבון בעת התאמת תרופות וטיפולים.
בחסות הפרויקט, והודות למאות מתנדבים שתרמו למדע דגימות מחיידקיהם הפרטיים, זיהו חוקרים ואפיינו את מגוון החיידקים השוכנים בגוף האדם הבריא, ופענחו את רצף הגנום שלהם. כך נבנו מאגרי נתונים גדולים, ופותחו כלי ניתוח חדשים להבנתם. שורה של מחקרים ניסתה למתוח קו בין מצבי בריאות וחולי לתמונת הרכב החיידקים. בין השאר בחנו את הקשר בין חיידקי המעי לבין מחלות מעיים דלקתיות כמו קרוהן; את השפעתם של חיידקי מערכת הרבייה הנשית על לידות מוקדמות; ואת הזיקה בין המיקרוביום האנושי לסוכרת, אלצהיימר, פרקינסון ועוד. עם הזמן חשפו החוקרים גם קשר בין שוכני המעיים להפרעות חרדה ומצב רוח. מכאן לכאורה הייתה אמורה להיסלל הדרך לטיפול: חוסר איזון חיידקי? נאזן אותו. אלא שמתברר שלכל איש יש שם - והרכב חיידקים משלו.
"המיקרוביום משתנה בין פרט אחד למשנהו. הוא כמו טביעת אצבע: קשה מאוד למצוא שני אנשים שיש להם בדיוק אותו הרכב חיידקים", מסביר ד"ר אמיר בשן, חוקר רשתות חיידקים מהמחלקה לפיזיקה באוניברסיטת בר־אילן. "אם אנחנו מדברים על סדר גודל של כמה אלפי מיני חיידקים שמתגוררים בגוף האדם, לכל אחד מאיתנו יש כמה מאות בכמויות משתנות. הבעיה היא שכאשר את הולכת לבית מרקחת לקנות לעצמך פרוביוטיקה לחיזוק הגוף, אף אחד שם לא עוצר אותך ושואל –'רגע, מה הרכב החיידקים אצלך? בואי נתאים את המוצר למיקרוביום האישי שלך'. זוהי למעשה ירייה באפלה. מעבר לכך, כשמבטיחים לך מיליוני חיידקים פרוביוטיים, זו כמות זניחה ביחס לטריליונים שיש לך בגוף. מחקרים שנערכו לאחרונה הראו אפילו שפרוביוטיקה עלולה להיות בעייתית", אומר בשן, ומכוון לשני מחקרים של מכון ויצמן, שהעלו כי הפעולה של 11 זנים ממשפחות החיידקים הפרוביוטיים הנפוצים משתנה מאדם לאדם, עד כדי השפעה בריאותית שלילית.
עם היעלמות החברים הוא חוגג ומתרבה בקצב מסחרר. חיידק C .diff

בשן עצמו לא צמח בעולם הבקטריולוגיה. הוא השלים שלושה תארים בפיזיקה באוניברסיטת בר־אילן ("ככה זה, פיזיקאים מכבדים את כוח האינרציה"), ואת הפוסט־דוקטורט כבר עשה בבית הספר לרפואה בהרווארד, במכון מחקר העוסק ב"רפואה מבוססת רשתות". מדע הרשתות, שנולד במאה ה־21, מושתת על ההבנה שכמעט כל מה שמתקיים על פני כדור הארץ הוא חלק מרשת המורכבת מהמוני פרטים. זו יכולה להיות רשת החשמל, רשת הכבישים, רשת התעופה, רשת הנוירונים במוח וגם רשת החיידקים. את כל אלה, מתברר, אפשר לנתח באותם כלים מתמטיים. גם אם אינטואיטיבית נראה שאין קשר בין תנועת המטוסים, מפות חלוקת הדואר והתנהגותם של יצורים חיים בתוך המעיים, ממעוף הציפור כולם משתייכים למשפחה מתמטית אחת.
"דמייני לעצמך ג'ונגל שמתקיים בו שיווי משקל אקולוגי", אומר בשן. "מה קובע כמה פרטים ממין מסוים יהיו? האינטראקציה שיש לו עם כל אחד מהמינים האחרים. האם הוא אוכל אותו, חי לצידו בשלום, או מתחרה איתו על משאבים. מתברר שהמערכת האקולוגית המורכבת ביותר נמצאת אצלנו בתוך המעיים. כל הזמן יש אינטראקציות בין חיידקים שונים: יש שמתחרים ביניהם על מזון שכמותו מוגבלת, יש מינים תוקפניים שמפרישים חומרים מסוימים כדי להרוג מינים אחרים, ויש חיידקים שדווקא נהנים זה מזה - אחד צורך את התוצר שחברו הפריש, ומשגשג יותר במחיצתו. כל האינטראקציות האלה מכתיבות כמה חיידקים יהיו מכל מין. אני כפיזיקאי מסתכל כביכול על תמונות של לוח שחמט במהלך משחק, ומנסה להבין מתוכן מה מערכת החוקים של המשחק".
המוטיבציה בחקר רשתות היא להצליח לשלוט בהן – ובמקרה של רשת החיידקים, המשמעות היא מניעת מחלות. אלא שכאן התעוררה בעיה: "כשהתחלתי להיכנס לתחום הזה, נתקלתי בשאלה יסודית מאוד. כאמור, לי ולך אין בדיוק אותם מיני חיידקים, וגם לא אותן כמויות. אבל האם החיידקים אצלי ואצלך כפופים לאותם חוקים? כדי לפענח את הרשת, אנחנו צריכים קודם להבין אם זו אותה רשת בכל המקרים, אחרת אנחנו בבלגן גדול. יש סיבות טובות לחשוב שההתנהגות של החיידקים תהיה זהה בכל המקרים - אם אצלי במעיים חיידק א' נלחם בחיידק ב', לכאורה למה שאצלך הם יהפכו את עורם? מצד שני, אנחנו מדברים על מערכת אקולוגית, וחלק מהאינטראקציות תלוי בסביבה שמשתנה - אני שותה הרבה קפה ואת לא, אורח החיים שלנו שונה, מערכת החיסון שלנו משחקת תפקיד אחר לגמרי. כשרצינו לחפש לזה תשובה, לא התייחסו אלינו. לחלק מהחוקרים היה ברור שזו רשת אחת, ואחרים היו משוכנעים שלא מדובר באותה רשת".

ד"ר אמיר בשן. | צילום: קרן עזריאלי
בהרווארד פיתח בשן שיטה מתמטית שנועדה לענות בדיוק על השאלה הזאת. מאות דגימות שנלקחו מבני אדם בריאים, הוכיחו כי למרות השונות הגדולה בין המארחים האנושיים, חוקי המשחק האקולוגיים של חיידקי המעיים דומים מאוד. בעור, אגב, הסיפור קצת אחר. כך או כך, הכלי החדש שפיתח בשן מאפשר לחקור גם אוכלוסיות חיידקים שלא בחרו בגוף האדם לאכסניה, אלא העדיפו אגמים, מדבריות ועוד.
לפני שלוש שנים פרסמו בשן ועמיתיו בכתב־העת החשוב Nature את תוצאותיו של מחקר שבו ראו במו עיניהם כיצד הרשת משתבשת. כוכב הניסוי היה C .diff, חיידק השוכן בכמות נאה בגופם של חמישית מהאנשים הבריאים וחי לו בשלום בקרבם. הבעיה איתו עשויה להתעורר כאשר מטופל מגיע לבית חולים בשל זיהום כלשהו שהתפתח ברגל, ביד או באיבר אחר, והרופאים, כדי לא לקחת סיכון, רושמים אנטיביוטיקה בעלת ספקטרום רחב. בכך לרוב מחוסל הזיהום, והחולה ממהר להתלוצץ עם רופאיו - אלא שלפעמים האנטיביוטיקה פוגעת בצורה משמעותית באוכלוסיית חיידקי המעיים. אותו C. diff חמקמק נהנה מעמידות לאנטיביוטיקה, ועם היעלמותם של החברים, הוא חוגג ומתרבה בקצב מסחרר עד כדי סכנת חיים למארחו.
"מה הרופאים עושים? נותנים עוד אנטיביוטיקה", אומר בשן. "כעת היא מסייעת בפחות משלושים אחוזים מהמקרים, והחיידק ממשיך לשגשג. אי אפשר להיפטר ממנו. אצל 17 מטופלים שלא הגיבו לאנטיביוטיקה, עשו שימוש בהשתלת צואה. כלומר, לקחו אוכלוסיית חיידקים מצואת אדם בריא, והשתילו בחולה. הטיפול עבד כמו קסם, ותוך ימים ספורים המטופל החלים. מה קרה כאן? ברגע שהגיעה אוכלוסייה בריאה של חיידקים אחרים, החיידק הזה הוריד את הראש, שב לכמות המתאימה ושלום על ישראל. אנחנו חקרנו את הרשת של הפציינטים לפני ההשתלה וראינו את הכאוס, הרשת לא תפקדה. כעבור ארבעה ימים בדקנו שוב את המערכת האקולוגית שלהם, והכול חזר למקום. זה היה מדהים". עם זאת כדאי לציין כי ביוני השנה פרסם מנהל המזון והתרופות האמריקני (FDA) אזהרה מפני הסיכונים הכרוכים בהשתלות צואה, וקבע הנחיות בטיחות מחמירות לאחר שכמה מקרים הובילו לזיהום ולמוות.
בינתיים ממשיך בשן לחקור בין כותלי המעבדה הישראלית את כללי השחמט הסבוכים. החיידקים, הוא מספר, נמצאים בראשו גם כשהוא חוזר הביתה. "מאז שהתחלתי לחקור אותם, אני מאוד מודע להם. כשאני אוכל, אני יודע שהם אוכלים עכשיו כל מה שאני מכניס לפה. אי אפשר להשתחרר מהם".
הקשיות נשלפות // פרופ' סיגל בן יהודה
במשך שנים ניסה המדע לפענח את מאפייניו ויכולותיו של כל חיידק בודד. ואז התברר שחיידקים יכולים גם לדפוק אצל השכנים, ולקבל מהם תכונות מועילות.
3.פרופ' סיגל בן־יהודה עמדה במעבדתה בהדסה עין־כרם וניסתה להבין מה היא רואה. מבעד לעדשת המיקרוסקופ זהרו תאי חיידקים שסומנו מבעוד מועד בצבע פלואורסנטי ירוק. עד כאן הכול הגיוני. אלא שבן־יהודה הבחינה שגם החיידקים השכנים, אלה שלא נצבעו, זרחו עכשיו באור נגוהות. המסקנה הייתה ברורה: מאחורי גבה עברו מולקולות מחיידק אחד למשנהו.
עצם קיומה של תקשורת בין־חיידקית היה ידוע בעולם המחקר עוד קודם, אבל הערוצים המשמשים לכך לא היו מוכרים על בוריים. "התחלנו לחשוב שיש משהו שאנחנו מפספסים", מסבירה בן־יהודה, חוקרת מהמחלקה למיקרוביולוגיה בפקולטה לרפואה של האוניברסיטה העברית. "מחקרים שערכנו גילו שהחיידקים מייצרים לעצמם ננו־צינורות ובאמצעותם הם יכולים להעביר זה לזה חומרים שונים, חלבונים וגם תכונות חיוניות, כמו למשל עמידות לאנטיביוטיקה. התקשורת הזו נוצרת כשהם יושבים יחד במצב נייח, לא כשהם שוחים. אם יש חיידק שעמיד לאנטיביוטיקה מסוג אחד, וחיידק שעמיד לאנטיביוטיקה אחרת, עצם העובדה שהם שכנים לספסל מאפשרת להם להעביר את התכונות ביניהם. כך נוצרת קהילת חיידקים שמוגנת מפני שני סוגי אנטיביוטיקה".
אחרי התגלית ההיא, שנרשמה בשנת 2011, הספיקה רשת ההברחה הבקטריאלית ליהנות מעוד כמה שנים של מסתורין. בינתיים חברה בן־יהודה לפרופ' אילן רוזנשיין, ויחד הצליחו השניים לפענח את המנגנון עצמו ואת הבסיס המולקולרי שמאחוריו. במחקרם הם מצאו לא רק איך מתקשרים החיידקים עם חבריהם לממלכה, אלא גם איך מתקשר חיידק עם התא שבחר לתקוף – בגוף האדם למשל. התגליות האלה זיכו את בן־יהודה ורוזנשיין במענק מחקר אירופי יוקרתי על סך 7 מיליוני אירו.
מחול ראווה מתואם להפליא. זרזירים

מחול ראווה מתאום להפליא. זרזירים. | צילום: שאטרסטוק
החיידק מתחבר ויונק מחברו כמו תינוק. מולקולות מועברות באמצעות צינורות

לפיצוח ערוצי תקשורת עשויות להיות השלכות דרמטיות חוצות דיסציפלינות, כמו פיתוח דרכים חדשות להילחם בחיידקים אלימים, או חיזוק חיידקים "טובים". ניתן גם לדאוג להעברת חומרים רצויים בצינורות המקובלים, וכך להנדס כרצוננו אוכלוסיות חיידקים בטבע או לצרכים חקלאיים.
"גילינו שהמערכת הזאת בנויה מצינורות ממברנליים, שלוחות של הממברנה (קרום התא – י"פ) של החיידק עצמו", אומרת בן־יהודה. "לאחרונה מצאנו שקומפלקס של חלבונים שקיים במינים רבים של חיידקים אחראי על יצירת השלוחות הללו. אנחנו מנסים עכשיו למצוא עוד רכיבים של אותה מערכת, לגלות מי עוד שותף למנגנון, אילו מולקולות עוברות דרכו. דבר נוסף ומרתק שגילינו הוא שהחיידק משתמש בצינורות האלה כדי 'לינוק' מהתא שמארח אותו. הוא מתחבר אליו ושותה ממנו כמו בקשית. כמעט בכל המערכות שהכרנו, החיידק נקשר לתא אחר ומשגר אליו חומרים, וכאן קורה דבר הפוך: הוא דואג לעצמו, לוקח אליו חומצות אמינו וחומרי מזון כדי לאפשר את הגידול שלו".

פרופ' סיגל בן־יהודה. | צילום: הדס פרוש, פלאש 90
אני מבינה שהחיידקים חברותיים משחשבנו, והם מתקשרים לא רק עם בני מינם.
"בשנים האחרונות אנחנו מגלים שהתקשורת בין החיידקים בטבע היא חזקה, ישירה ומפתיעה מאוד. הם מעבירים זה לזה מולקולות בדרכים שאנחנו אפילו לא מעלים בדעתנו, ויש להם יכולת מופלאה להסתגל וליצור קהילה שמורכבת ממינים שונים, מה שמגדיל מאוד את המורכבות של האוכלוסייה. בעידן ה'קלאיסי' היינו לוקחים חיידק אחד, ולומדים עליו כל מה שאפשר: האם הוא עמיד לאנטיביוטיקה או לא, מייצר חומצת אמינו או לא מייצר. ברגע שהבנו שחיידק יכול להיות חלק מקהילה, המידע שצברנו עליו לא מספיק, כי יש לו שכנים שהוא יכול לדפוק אצלם בדלת ולבקש מה שהוא צריך. קשה לנו לצפות מה יקרה בתוך אוכלוסייה מגוונת, איך היא תתמודד עם תנאי עקה – אנטיביוטיקה, למשל – או אילו ויטמינים ורעלנים יעברו בתוך המערכת. חיידקים הם באמת מעוררי השתאות".
גם אחרי שלושה תארים באוניברסיטת תל־אביב ופוסט־דוקטורט בהרווארד (במעבדתו של ריצ'רד לוסיק, מהמיקרוביולוגים החשובים ביותר בעולם), בן־יהודה לא מפסיקה להתפעל ממושאי מחקרה. "אני מתה עליהם. קודם כול הם יפים מאוד, אפשר להתמוגג רק מלראות אותם. מעבר לכך, כמעט כל מערכת ומנגנון מורכב שמצאנו אצל בני האדם, בסוף גילינו מערכת דומה אצל החיידקים. הם יכולים לגדול בכל מקום, הם יעילים ומהירים, הם פשוט מוצלחים יותר. כל מה שאנחנו יודעים על תהליכי התא, כל הביולוגיה המודרנית, כל ההנדסה הגנטית והשיבוט - הכול למדנו תחילה מהחיידקים, ואז השלכנו על מערכות מורכבות יותר".
הלהקה עולה להופיע // פרופ' אברהם באר
זנבות באורך ננומטר מאפשרים לחיידקים לנוע במרחב. התוצאה היא מחול מרהיב של מאות פרטים, שמצליחים לגבור על פקקי התנועה
4.עם בוא החורף מתחשרים שוב שמי הארץ - ושמי האינטרנט - בעננים שחורים המתפשטים ומתהדקים בקצב מסחרר: להקות עצומות של אלפי זרזירים מפגינות תעלולים אווירודינמיים בתיאום מושלם, מבלי שיתנגש זרזיר ברעהו. מחול הראווה הזרזירי מצטרף לשלל מופעי טבע פוטוגניים אולי קצת פחות – של יונים, אווזים, ואפילו להקות דגים בים. גם החיידקים, מתברר, לא טומנים ידם בצלחת הפטרי. אלה מהם שניחנו בכושר תנועה, שוחים בתנועה מתואמת עם מאות אחיהם למושבה כדי להתקדם לעבר ארוחה או לברוח מאויב.
הקולקטיב החיידקי מככב לא מעט בפרסומים המדעיים המקומיים, וגם תנועת החיידק הבודד קיבלה נפח מחקר משמעותי. אבל על נושא התנועה הקולקטיבית שוקד כיום רק חוקר ישראלי אחד - פרופ' אברהם באר, חבר המחלקה לפיזיקה באוניברסיטת בן־גוריון והמכון לחקר המים בשדה־בוקר. לפני שנדבר על המשחֶה ההמוני, הוא מספר על השחיין הבודד. "החיידקים שאני עובד איתם ומינים רבים אחרים נראים אותו דבר מבחינה חיצונית: מוט קצר מאורך, מעין גרגר אורז. וכמו שהאורז יכול להיות בסמטי או תאילנדי או פרסי, כך גם כאן - יש חיידקים ארוכים, יש קצרים יותר ויש כדוריים. לכל אחד מהם יש שוּטונים, זנבות שממוקמים בדרך כלל באחד מקצות הגרגר. למוט שלנו יש כושר שחייה עצמוני, והשוטונים משמשים לו מעין הגה - כשהוא מחליט לנוע קדימה הוא מסובב שוטון אחד, וכדי לשנות כיוון הוא משתמש בשוטון אחר. כך הוא מנתב את התנועה שלו, בפרט כשהוא בתוך גוף של מים, ולא 'רואה' מימינו ומשמאלו".
משמשים מעין הגה. שוטונים מסתלסלים מחיידקי בצילוס סבטיליס


אם גודלו של החיידק הוא בקנה מידה של מיקרון, אחד חלקי מיליון ממטר, השוטונים שלו הם ננומטריים, אחד חלקי מיליארד. לולא באו לעולם מיקרוסקופים חדישים, היו הזנבות נשארים בלתי נראים בעליל. היום, למשל בעזרת מיקרוסקופ פלואורסנטי – שעל שדרוגו הוענק פרס נובל בשנת 2014 – ניתן לחזות בשוטון במלוא תפארתו, אם ייצבע מראש בצבע זרחני. מכאן ועד להבנת פעולתו של זנב האורז, הדרך הייתה קצרה.
"ההתבוננות בשוטון לימדה אותנו כמה החיידק הוא משוכלל. תחשבי רגע על בורג: תמיד כשתסובבי אותו ימינה הוא יינעץ, ואם תסובבי אותו שמאלה הוא ייחלץ. לסליל שבו יש רק אפשרות אחת. אותו דבר קורה עם השוטונים. יש להם מעין מנוע שמחבר אותם לגרגר האורז, כך שכאשר הם מסתובבים נגד כיוון השעון, החיידק שוחה קדימה. בסיבוב עם כיוון השעון הזנב נעשה רפוי, כמו גומייה משוחררת, והחיידק נעצר במקומו עד שהוא בוחר כיוון חדש ומתחיל לנוע שוב. יש לו מצפן משלו, מערכת חישה כימית שמסמנת לו אם הוא בכיוון הנכון – לעבר מקור אוכל, למשל - או בכיוון הלא נכון, ואז צריך לחשב מסלול מחדש".
לא כל החיידקים מסוגלים לנוע. הסטרפטוקוקוס, זה שמתיישב לנו בגרון לא פעם, מסתדר יפה ללא שוטונים וללא תזוזה: או שיינשא על פני נוזל, או שסתם ירבוץ. מושבת הסטרפטוקוקים תיראה יותר כמו גוש, ופחות כמו ענני זרזירים. בקרב קהילת השחיינים, לעומת זאת, שמחה והילולה. "לראות מושבה במיקרוסקופ זה באמת תאווה לעיניים, מראה יפהפה לא פחות מלהקות הציפורים והדגים", אומר באר. "חיידקים נעים כגוש אחד, בתיאום מדויק. המנח שלהם מתואם, כמו עפרונות ארוכים ששוכבים זה לצד זה. אחרי כמה שניות הגוש יכול להתפרק - ממש כמו להקת יונים, שחלק מהן פונות לעבר הגג בזמן שאחרות נוחתות על הקרקע. החיידקים מתקבצים ושוב מתפצלים, כמה מאות הולכים לשם וכמה עשרות לשם. האם לדעתך הם זזים מהר יותר או לאט יותר כשהם בתוך הצביר הזה?"

אינטואיטיבית הייתי אומרת שלאט יותר.
"אז אחת התופעות הכי מעניינות ומוזרות היא שככל שהצפיפות עולה, הם זזים מהר יותר. נשמע לא הגיוני, כי אם יש המון מכוניות על הכביש, אתה נתקע. אצל חיידקים זה הפוך. יש כאן יתרון אבולוציוני לצפיפות, שעושה אותם למשל עמידים יותר לאנטיביוטיקה. ככל שהם צפופים יותר, האינטראקציה ביניהם חזקה יותר, והחיידק הבודד משועבד יותר לקבוצה".
את התצפית על הקולקטיב נוח כמובן לעשות כשהמושבה היא שטוחה ודו־ממדית, אלא שיש גם מושבות חיידקים תלת־ממדיות. אחד המחקרים האחרונים שהוביל באר בדק מה משמעות המבנה מבחינת העמידות לאנטיביוטיקה: התברר שברגע שאיום כזה מופיע בסביבה, חיידקי התחתית פשוט נמלטים לחלק האמצעי של המושבה, וכך מצליחים להינצל.
"התנועה הקולקטיבית של החיידקים, bacterial swarming כפי שאנחנו קוראים לה, היא לשמחתי בור מחקרי ללא תחתית", חותם באר. "אנחנו במעבדה ממשיכים לחפור, ומגלים בו בכל פעם דברים חדשים".
// פרופ' ג'וזפה פליני ופרופ' בעז פוקרוי
במעבדה זעירה בתוך לוויין יתחולל בקרוב דו־קרב אימתני בין חיידקים לחלבונים. תוצאותיו יאפשרו להציל אסטרונאוטים ממחלות קשות, במקום הרחוק ביותר מכל בית חולים
5.אם הכול ילך כמתוכנן, בעוד כמה שבועות יוצב טיל על כן שיגור בגינאה שבאפריקה, וימריא לחלל כשהוא נושא איתו כמה לוויינים זעירים. אחד מהם יכיל מיני־מעבדה שתוכננה בקפידה על ידי פרופ' בעז פוקרוי מהטכניון ופרופ' ג'וזפה פליני מאוניברסיטת בולוניה - כיאה ליוזמה משותפת של סוכנות החלל הישראלית ואחותה האיטלקית.
מה במעבדה? תמיסה שבה גרים בכיף חיידקי מיקרוקוקוס ליזודאיקטיקוס, הידועים במנהגם לחולל מחלות. בתוך תא קטנטן מאופסנים חלבונים בשם ליזוזַיים, המשמשים שחקני הגנה משובחים מול אותו חיידק, אם הוא חודר לגוף האדם. את השם לחלבון הלוחם, שפירושו "אנזים מֵמֵס", העניק ממציא האנטיביוטיקה הראשונה, אלכסנדר פלמינג. הרופא הסקוטי גילה את האנזימים הללו בריר אף של פציינט מצונן, וראה איך הם ממסים מיקרוקוקוסים בצלחת פטרי.
ממעבדת החברה הישראלית "ספייס פארמה" יעקבו פוקרוי ופליני אחרי הלוויין. כשייכנס למסלול סביב כדור הארץ, יזריקו השניים בשלט רחוק את תמיסת החיידקים האלימים לתוך אגף החלבונים האנטי־בקטריאליים, ויאללה בלגן. "את הדו־קרב בין הצדדים האלה אנחנו כבר מכירים", מסביר פוקרוי, איש הפקולטה למדע והנדסה של חומרים בטכניון. "אנחנו יודעים מה הליזוזיים מעולל לחיידקים: הוא מפרק להם את הממברנה וכך מחסל אותם. המטרה שלנו היא לראות מה יקרה באפס כבידה. עבודות מהשנים האחרונות הראו שבמצב כזה יש שינויים באינטראקציות ביניהם. אני בעצם מנסה להבין מהי הקינטיקה, מה קצב התגובה של החלבון מול האיום: האם הוא יהיה מהיר יותר או איטי יותר בחלל? ניסוי כזה מאפשר לנו לבודד משתנים, ולהוציא מהמשוואה את אחד הגורמים החשובים שיכולים להשפיע על קצב התגובה – הקונבקציה, כוח ההסעה - כיוון שהוא קשור בכוח הכבידה של כדור הארץ".
מיני־מעבדה שתוכננה בקפידה. לוויין זעיר של חברת "ספייס פארמה"

מיני־מעבדה שתוכננה בקפידה. לוויין זעיר של חברת "ספייס פארמה". | צילום: SpacePharma
מה תרומתו של הניסוי הזה לאנושות?
"קודם כול, יש פה מדע בסיסי. אני מעלה שאלה מדעית שהתשובה עליה לא ידועה לי, ולומד את מה שקורה. זה היופי במדע. אם את שואלת על יישום פרקטי, הדבר הראשון שאני יכול לחשוב עליו אלה האסטרונאוטים שנשלחים לחלל. אנחנו יודעים בוודאות שחיידקים יכולים לשרוד מחוץ לאטמוספרה, ומניסויי עבר אנחנו רואים שהעמידות שלהם לאנטיביוטיקה משתנה שם. לפני שאנחנו משגרים אנשים, כדאי לדעת מה האיומים ואיך לטפל בהם".
לפני כשנתיים החליטו חוקרים מאוניברסיטת קולורדו לגדל במכלים גדולים בתחנת החלל הבינלאומית את חיות המודל החביבות על המיקרוביולוגים – חיידקי אי־קולי. בביתם החדש קיבלו החיידקים מנות נדיבות של אנטיביוטיקה, והממצאים היו מפתיעים: התברר שחיידקי החלל הכפילו את כמותם פי 13 ביחס למקביליהם הארציים, ושרדו את המתקפה בגבורה. כדי לחסל אותם נדרשו ריכוזים גבוהים מאוד של אנטיביוטיקה. בין ארבעת הניסויים שיצאו לדרך על הטיל שתשגר סוכנות החלל האירופית, ישנו מחקר ישראלי־איטלקי נוסף, בניצוחו של פרופ' אוהד גל־מור מבית החולים שיבא, שיבחן גם הוא עמידות לאנטיביוטיקה.

פוקרוי עצמו הוא מהנדס חומרים שהשלים שלושה תארים בטכניון. במהלך פוסט־דוקטורט בהרווארד נחשף לתחום החיידקים - או ליתר דיוק, לניסיון למגר אותם באמצעות חומרים שונים. במעבדתו הוא עוסק בין היתר בייצור משטחים וציפויים שמונעים מחיידקים להיצמד אליהם ולהתבסס עליהם. "אנחנו עושים זאת באופן פסיבי, כלומר ללא רעלים ואנטיביוטיקה. יצרנו למשל חיקוי למשטח שקיים בטבע: על פני השטח של עלים בצמחים מסוימים, אנחנו מוצאים צבר של גבישי שעווה. המפורסם שבהם הוא הלוטוס, שמוכר בזכות תופעה של ניקוי עצמי: מים לא מרטיבים אותו, הם פשוט מתגלגלים ממנו למטה, בגלל בליטות מיקרוסקופיות שלא מאפשרות להם ליצור מגע. התחלנו לייצר משטחים עם גבישים כאלה באופן סינתטי, וראינו שהחיידקים פשוט לא מצליחים להתבסס עליהם, על אף שאין שום חומר רעיל. אנחנו מקווים לפתח את זה למוצר תעשייתי – למשל ספריי שימנע הצטברות חיידקים, ויעשה זאת בלי לפגוע בסביבה".
מה לגבי ריהוט מוגן מחיידקים לבתי חולים?
"אני חושב שהיישום הכי חשוב הוא ציפוי פנימי של מערכת האוורור בבתי חולים. זה המקום בה"א הידיעה להתבססות חיידקים, ובכל זאת אני לא מכיר בית חולים שמנקה את הצנרת של מיזוג האוויר למשל. אנחנו גם בקשר עם רשתות מזון. השעווה שייצרנו קיבלה אישור FDA שהיא לא מסוכנת לאכילה, ואנחנו רוצים לייצר משטחי עבודה ואריזה שבהם לא תהיה סכנה של ריכוזי חיידקים. בתחום הנדסת החומרים, השמיים הם הגבול".